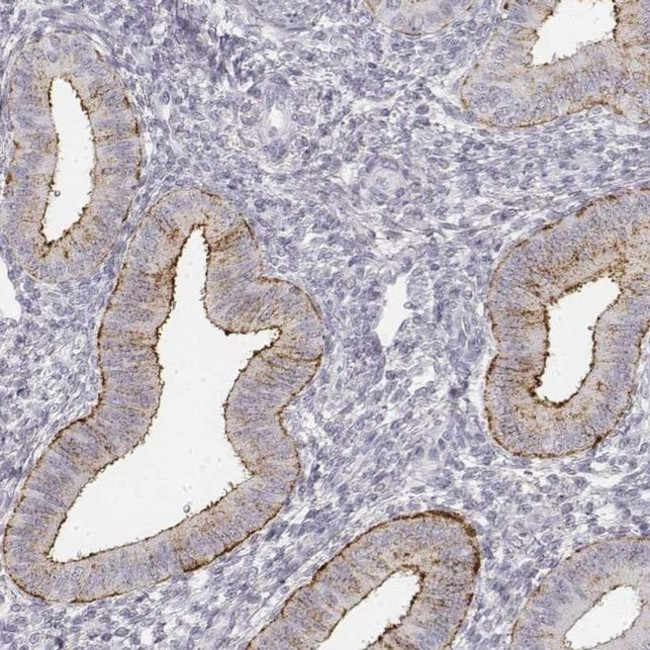
KRT84 Antibody in Immunohistochemistry (IHC)

Search
Invitrogen
KRT84 Polyclonal Antibody
{{$productOrderCtrl.translations['antibody.pdp.commerceCard.promotion.promotions']}}
{{$productOrderCtrl.translations['antibody.pdp.commerceCard.promotion.viewpromo']}}
{{$productOrderCtrl.translations['antibody.pdp.commerceCard.promotion.promocode']}}: {{promo.promoCode}} {{promo.promoTitle}} {{promo.promoDescription}}. {{$productOrderCtrl.translations['antibody.pdp.commerceCard.promotion.learnmore']}}
产品信息
PA5-65244
种属反应
宿主/亚型
分类
类型
偶联物
形式
浓度
规格
纯化类型
保存液
内含物
保存条件
运输条件
RRID
产品详细信息
Immunogen sequence: CGVRFGAGCGM GFGDGRGVGL GPRADSCVGL GFGAGSGIGY GFGGPGFGYR VGGVGVPAAP SITAV
Highest antigen sequence identity to the following orthologs - mouse 61%, rat 62%.
靶标信息
The Keratin multigene family is made of "soft" epithelial cytokeratins and "hard" hair Keratins. While the epithelial cytokeratins are involved in the layering and formation of epithelia, the hair Keratins are responsible for creating nails and hair. There are two types of Keratins: the acidic class I Keratin proteins and the basic/neutral class II Keratin proteins. Keratin 84, also known as KRT84, HB4 or KRTHB4, is a 600 amino acid protein that is expressed in hair follicles. Keratin 84 is a basic/neutral type II Keratin protein which heterodimerizes with type I Keratins to create hair and nails. The gene encoding Keratin 84 maps to human chromosome 12 which encodes over 1,100 genes and comprises approximately 4.5% of the human genome. Chromosome 12 is associated with a variety of diseases and afflictions, including hypochondrogenesis, achondrogenesis and Kniest dysplasia.
仅用于科研。不用于诊断过程。未经明确授权不得转售。
篇参考文献 (0)
生物信息学
蛋白别名: hard keratin, type II, 4; K84; keratin 84, type II; keratin, hair, basic, 4; Keratin, type II cuticular Hb4; Keratin-84; type II hair keratin 4; Type II hair keratin Hb4; Type-II keratin Kb24; unnamed protein product
基因别名: HB4; KRT84; KRTHB4
UniProt ID: (Human) Q9NSB2
Entrez Gene ID: (Human) 3890